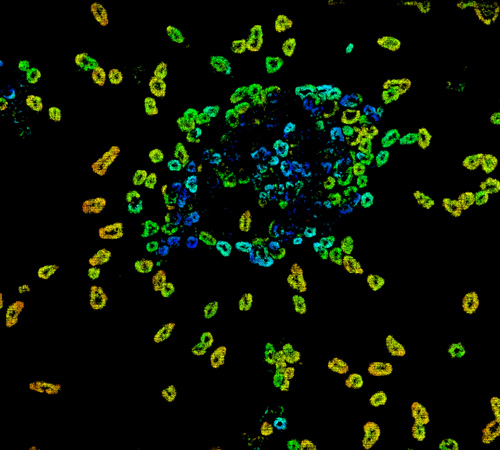

- 提供配置文件
- 光场摄像头是一种新型3D摄像头,它捕捉标准图像并同时获取场景深度信息矩阵3D信息可用单光场摄像头单拍Raytrix专门开发光场摄像头用于工业应用
产品组合
LightField技术

-
4.0三维局部检测
-
- 对自动化光学检验系统的需求也在持续增长,这些系统也包含第三维使用Raytrix光场摄像头,你不仅能用2D测量3D并用单摄像头测量,单拍并使用标准照明why not替换二维相机当前AOI系统与3D相机相同大小
-
三维平面分析
-
- 二维图像和三维形式植物可捕捉光线或近红外线以确保测量不干扰植物生长系统还强室外使用,因为只需要单图像植物运动,例如风能运动不成问题
-
3DFLID气象
-
- 单Raytrix光场PTV摄像头可同时捕捉3D粒子位置和3D粒子速度光栅摄像头使用专利微镜数组设计最优组合场间深度有效解析
-
3D运行程序
-
- Raytrix摄像头扩展深度小脚印并用单片摄像头捕捉2D3D数据的能力将Raytrix光场摄像头安装到终端效果器上以测量深度并摄取图像,甚至在近距离
-
三维MICROSCOPY
-
- 标准显微镜并想用3D测量无问题-装上Raytrix3D显微镜只需要单摄像头 单拍标准点灯 框架速率受摄像头电子约束
-
8K高分辨率
-
- 分辨率42兆像素,摄像头尺寸40x40x27mm和USB3连接:这是2D摄像头C42最适宜应用不遗漏细节,例如安全性检查、PCB检验、机器人数组和相机数组摄像头可用C-mount并用集成高分辨率光学
3D现场摄影机解析
3D现场摄像头
-






8/R42SERIES
-
- R42高分辨率光场摄像头以42兆米传感器为基础,7fs提供多达10兆像素有效解析
传感器
- 分辨率:42兆像素,7716x5364像素
- 有效解析达10兆像素
- 像素大小:1.12m像素
- CMOS滚接门
- 颜色,HDR
包件整理
- USB3接口
- 最高7FS
- 尺寸39x39x31.2毫米
- 装机
MICROLENSARAYS
-






R12/R25/R50VIDEOSERIES
-
- R12为传感器解析12大射线提供最高框架速率,结果60fs有效解析3兆像素(R25提供625MP@80FPS)。
传感器
- 分辨率:12大射线4096x3068像素
- 有效解析达3兆像素
- 像素大小: 5.5m平方像素
- CMOS全局开机
- 单色,颜色,NIR
包件整理
- 相机链路接口
- 最高60fs
- 尺寸71.8x75.5x28.7毫米
- f-mountM58
MICROLENSARAYS
-






R29/R47SERIES
-
- R29高低噪声像素需要高质输出高有效解析即为正确选择摄像头也是PIVPTV客户标准选择
传感器
- 分辨率: 29兆像素, 6576x4384像素
- 有效解析达7兆像素
- 像素大小: 5.5m平方像素
- CCD全局开机
- 单色,颜色,NIR
包件整理
- 双GigE接口达5.9fps
- CamLink接口达5.9fps
- 尺寸70x71x55.4毫米
- f-mountM58
MICROLENSARAYS
-






R5SERIES
-
- 这是我们摄像头最低传感器分辨率但框架速率最高最优适配型图像捕捉量达180fs
传感器
- 分辨率:4大射线2048x2048像素
- 有效解析达1兆像素
- 像素大小: 5.5m平方像素
- CMOS全局开机
- 单色NIR
包件整理
- 双GigE,USB3.0,相机链路接口
- 最高180fs
- 尺寸,52x52x37毫米
- 装机
MICROLENSARAYS
- 玻璃聚合器
- 孔径:f/2.4、f/5.6、f/260或定制版
三维MICROSCOPY摄像头
- 标准显微镜并想用3D测量无问题-装上Raytrix3D显微镜只需要单摄像头 单拍标准点灯 框架速率受摄像头电子约束
-






R10MICRO服务
-
- R10显微机设计用显微镜低噪声高分辨率单色输出避免贝叶尔模式人工制品传感器分辨率10兆像素允许有效分辨率达2.5兆像素
传感器
- 分辨率: 10兆像素, 3840x2672像素
- 有效解析至2.5兆像素
- 像素大小:2.24m方形像素
- CMOS滚接门
- 单色
包件整理
- USB3接口
- 最高7FS
- 尺寸39x39x31.2毫米
- 装机
MICROLENSARAYS
-

R12MICRO服务
-
- R12显微机专用显微镜相仿大像素3.1微米和传感器分辨率12兆像素产生传感器尺寸最优用于标准显微镜3兆像素有效解析允许大范围放大
传感器
- 分辨率: 12兆像素, 4224x2838像素
- 有效解析达3兆像素
- 像素大小:3.1m方形像素
- CCD全局开机
- 单色色
包件整理
- GigE接口
- 达5.5fs
- 尺寸38x38x45毫米
- 装机
MICROLENSARAYS
二维高分辨率摄像头
- 分辨率42兆像素,摄像头尺寸40x40x27mm和USB3连接:这是2D摄像头C42最适宜应用不遗漏细节,例如安全性检查、PCB检验、机器人数组和相机数组摄像头可用C-mount并用集成高分辨率光学
-






C42SERIES
-
- C42COLOR/MONO高分辨率二维摄像头基于42兆像素传感器和最高达7fs高分辨率微小到任何地方都可用
传感器
- 分辨率:42兆像素,7716x5364像素
- 像素大小:1.12m像素
- CMOS滚接门
- 颜色,HDR
包件整理
- USB3接口
- 最高7FS
- 尺寸39x39x31.2毫米
- 装机
-






C42ISERIES
-
- C42i二维传感器基础与C42相同高分辨率42兆像素2D传感器,然而,它特征综合透镜使其更加紧凑
传感器
- 分辨率:42兆像素,7716x5364像素
- 像素大小:1.12m像素
- CMOS滚接门
- 颜色,HDR
包件整理
- USB3接口
- 最高7FS
- 尺寸39x39x31.2毫米
- 集成镜片
三线现场摄像头专业应用
-

FLOW PIVPTV
-
- 完全新用途
单Raytrix光场PTV摄像头可同时捕捉3D粒子位置和3D粒子速度光栅摄像头使用专利微镜数组设计最优组合场间深度有效解析
单片VOLUMETIGPTV
三维粒子定位和三维速度单摄像头
易元化解析
相机很容易用Raytrix软件RxLive测量
变量应用
多不同摄像头类型可用包括双拍、高速抓取和微PTV
-

局部观察
-
- 完全新用途
单光场3D摄像头可同时捕捉3D对象表面和2D对象图像Raytrix摄像头使用专利微镜数组设计扩展场深度比标准相机高并提供高有效解析度,使它们成为市场中最高分辨率光场摄像头
二维三维数据
标准二维图像和三维表面剖面可用单片摄像头计算
快速图像摄像头
仅需要单图像,图像可高架率摄取,并带闪光
向其它三维系统无法向
最适宜小对象或深层结构
LightFieldCAMERA技术
-
-
是什么
- 光场摄像头能同时记录二维图像 并用单摄像头和单主镜头对三维深度信息
通常使用标准照明甚至闪存难面可使用模式投影器接触时间受摄像头电子和可用光量限制摄像头内部不处理,简单向PC发送原始图像,然后GPU处理获取2D3D数据
原则上,我们可以把任何摄像头转换成光场摄像头通常,我们的股市摄像头 将满足您的需要有USB3GigE或CamLink连接类型,带不同框架率、分辨率和传感器尺寸多数摄像头均配有色单版本,有些则配有NIR版查看产品页面以完整概述
-
如何工作
- 从单片获取2D3D数据主要需要两样东西:微镜数组和软件算法
图像传感器前置摄像头,将图像传感器转换成微摄像阵列(见右侧图),每个微摄像头从略微不同的角度观察中间图像的一部分即不使用直视对象的大相机阵列,我们可以选择主镜头选择理想视域并创建微相机阵列前中间图像摄像头生成的图像由PC处理,并配有适当的软件算法计算场景深度并重构二维图像
gPU处理所有图像, 允许我们典型处理512兆维原始图像秒数, 产生三三兆像素二维三维图像秒数(30FPS)。
-
为何我要使用
- 三维光场摄像头对小对象特别有效可使用标准透镜、远程中心透镜或显微镜选择视觉深度解析专利微镜数组最优组合高有效分辨率和广深场自你只需要单摄像头和单拍
- 估计三维位置深度嵌入圆柱圈
- 使用闪光或strobe高速率取动对象图像
- 三维数据单片通过标准显微镜获取
有效横向解析度最多为传感器解析度的四分之一,深度解析度约为全深度的1%绝对值依赖主镜头使用典型应用区有:
- 自动化光3D检验行业
- 三维流测量流流流流流体机研究单点
- 3D植物分析播种、采摘或除草
- 三维显微镜处理工业零件
-
什么东西
- 免费定理也应用在这里:您可以单拍获取2D3D数据,但以有效横向解析支付摄像头最大有效横向解析约四分之一传感器解析有效平面解析法在整个广度上也互不相同摄像头设置时将主镜头聚焦最远平面从平面向相机计算深度并重构二维图像后方无法重构的一切有效横向分辨率最高点为焦平面和下降
深度分辨率通常为全深度的1%,转而取决于主镜头焦点长度和焦点设置可选择不同的主镜头同光场摄像头调整场深度以适应需求越大视野越广 深度越广 距离主透镜越近 获取深度清晰度特别是,这意味着光场摄像头与广角透镜相联,只能看到深度差接近主镜
光场摄像头在宏域内工作良好,用显微镜和望远镜工作良好。